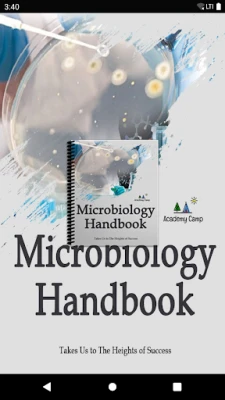

नवीनतम संस्करण
अपडेट
फ़रवरी 16, 2026
फ़रवरी 16, 2026
डेवलपर
Academy Camp
Academy Camp
श्रेणियाँ
शिक्षा
शिक्षा
प्लेटफ़ॉर्म
एंड्रॉइड
एंड्रॉइड
डाउनलोड
0
0
लाइसेंस
Free
Free
पैकेज का नाम
com.academycamp.app.michb
com.academycamp.app.michb
रिपोर्ट
समस्या की रिपोर्ट करें
समस्या की रिपोर्ट करें
Microbiology Handbook के बारे में और जानें
"The Handbook of Microbiology" आपको सूक्ष्मजीवों जैसे वायरस, बैक्टीरिया, शैवाल, कवक, स्लाइम मोल्ड और प्रोटोजोआ के बारे में जानने में मदद करता है। इसमें इन सूक्ष्म जीवों के अध्ययन और हेरफेर के तरीकों का भी वर्णन है।
सूक्ष्मजीव विज्ञान की अद्भुत दुनिया में आपका स्वागत है, एक ऐसा क्षेत्र जो हमारे आस-पास के अदृश्य जीवन और मानव अस्तित्व पर इसके गहरे प्रभावों को उजागर करता है। यह केवल किताबों तक सीमित विज्ञान नहीं है, बल्कि एक गतिशील अनुशासन है जो लगातार नवाचार को बढ़ावा देता है और जीवन की गुणवत्ता को बेहतर बनाने के लिए सूक्ष्मजीवों की शक्ति का उपयोग करता है। प्रारंभिक खाद्य उद्योग से लेकर आज के अत्याधुनिक अपशिष्ट प्रबंधन, आनुवंशिक इंजीनियरिंग और अन्य क्षेत्रों तक, सूक्ष्मजीवों की भूमिका लगातार विकसित हो रही है, जो हमें पर्यावरण और स्वास्थ्य के लिए नए समाधान खोजने में मदद करती है। यह ज्ञान का एक ऐसा खजाना है जो आपको प्रकृति के सबसे छोटे लेकिन सबसे शक्तिशाली एजेंटों को समझने में सशक्त करेगा।
यह व्यापक संसाधन आपको सूक्ष्मजीव विज्ञान के हर पहलू की गहराई में ले जाता है। आप विषय की बुनियादी बातों से शुरुआत करेंगे, जिसमें परिचय, रसायन विज्ञान और सूक्ष्मदर्शी के उपयोग जैसे महत्वपूर्ण उपकरण शामिल हैं। इसके बाद बैक्टीरिया, आर्किया और यूकेरियोट्स की जटिल कोशिका संरचना, चयापचय और आनुवंशिकी का पता लगाएंगे। विषाणुओं के रहस्य, महामारी विज्ञान के सिद्धांत और प्रतिरक्षा प्रणाली की जटिल कार्यप्रणाली को विस्तार से समझाया गया है। चाहे वह सूक्ष्मजीवों का संवर्धन हो, रोगजनकता को समझना हो, या औद्योगिक और पर्यावरणीय अनुप्रयोगों का पता लगाना हो, यहाँ प्रत्येक विषय को स्पष्टता और गहनता से प्रस्तुत किया गया है, जिससे आपको इस क्षेत्र की एक समग्र समझ मिलेगी।
यह बहुमूल्य जानकारी छात्रों, शोधकर्ताओं और इस महत्वपूर्ण विज्ञान में रुचि रखने वाले किसी भी व्यक्ति के लिए एक आदर्श साथी है। यह आपको सूक्ष्मजीवों की दुनिया में एक विशेषज्ञ बनने की दिशा में मार्गदर्शन करेगा, जो आधुनिक विज्ञान और नवाचार में उनकी केंद्रीय भूमिका की गहरी प्रशंसा प्रदान करेगा। इस समृद्ध शैक्षिक सामग्री का स्रोत, Readium Project, अपने मुक्त-स्रोत (open-source) दृष्टिकोण के लिए जाना जाता है, जो ज्ञान को सभी के लिए सुलभ बनाने की प्रतिबद्धता को दर्शाता है। गुणवत्तापूर्ण और विश्वसनीय सीखने के अनुभव के लिए आज ही इस ज्ञान यात्रा का हिस्सा बनें।
यह व्यापक संसाधन आपको सूक्ष्मजीव विज्ञान के हर पहलू की गहराई में ले जाता है। आप विषय की बुनियादी बातों से शुरुआत करेंगे, जिसमें परिचय, रसायन विज्ञान और सूक्ष्मदर्शी के उपयोग जैसे महत्वपूर्ण उपकरण शामिल हैं। इसके बाद बैक्टीरिया, आर्किया और यूकेरियोट्स की जटिल कोशिका संरचना, चयापचय और आनुवंशिकी का पता लगाएंगे। विषाणुओं के रहस्य, महामारी विज्ञान के सिद्धांत और प्रतिरक्षा प्रणाली की जटिल कार्यप्रणाली को विस्तार से समझाया गया है। चाहे वह सूक्ष्मजीवों का संवर्धन हो, रोगजनकता को समझना हो, या औद्योगिक और पर्यावरणीय अनुप्रयोगों का पता लगाना हो, यहाँ प्रत्येक विषय को स्पष्टता और गहनता से प्रस्तुत किया गया है, जिससे आपको इस क्षेत्र की एक समग्र समझ मिलेगी।
यह बहुमूल्य जानकारी छात्रों, शोधकर्ताओं और इस महत्वपूर्ण विज्ञान में रुचि रखने वाले किसी भी व्यक्ति के लिए एक आदर्श साथी है। यह आपको सूक्ष्मजीवों की दुनिया में एक विशेषज्ञ बनने की दिशा में मार्गदर्शन करेगा, जो आधुनिक विज्ञान और नवाचार में उनकी केंद्रीय भूमिका की गहरी प्रशंसा प्रदान करेगा। इस समृद्ध शैक्षिक सामग्री का स्रोत, Readium Project, अपने मुक्त-स्रोत (open-source) दृष्टिकोण के लिए जाना जाता है, जो ज्ञान को सभी के लिए सुलभ बनाने की प्रतिबद्धता को दर्शाता है। गुणवत्तापूर्ण और विश्वसनीय सीखने के अनुभव के लिए आज ही इस ज्ञान यात्रा का हिस्सा बनें।
ऐप को रेट करें
टिप्पणी और समीक्षा जोड़ें
उपयोगकर्ता समीक्षाएं
0 समीक्षाओं पर आधारित
अभी तक कोई समीक्षा नहीं जोड़ी गई है।
यदि टिप्पणियाँ स्पैम, अपमानजनक, विषय से हटकर, अभद्र भाषा का उपयोग करती हैं, व्यक्तिगत हमला करती हैं, या किसी भी प्रकार की घृणा को बढ़ावा देती हैं, तो उन्हें पोस्ट करने के लिए स्वीकृत नहीं किया जाएगा।
अधिक »










लोकप्रिय ऐप्स

Librera PRO: किताब पढ़ने वालाLibrera

Moglix - बी2बी और बी2सी शॉपिंगMogli Labs India Pvt. Ltd.

Fuelio: Fuel log & fuel pricesSygic.

Bengali Matrimony Marriage AppMatrimony.com Ltd.

VCB DigibankVietcombank

इम्यूनोलॉजी पाठ्यक्रमAPLUS

Immune WarCrazyTaowa

AUTOsist Fleet Maintenance AppAUTOsist

The Hindu ePaper: eNewspaperTHG Publishing Private Limited

डिजिखटा - आय खर्च & बजट बुकDigiKhata Business Apps